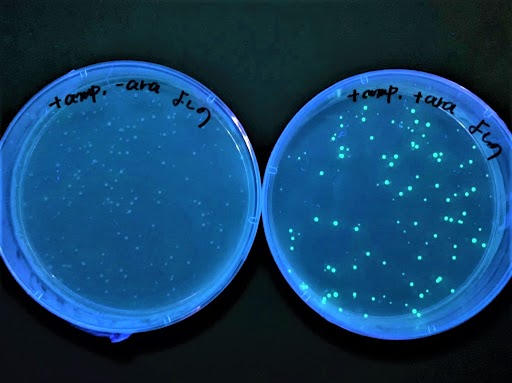
光る大腸菌！？DNA実験に挑戦してみよう！

7月18日
半日体験
気になる分野を選んでイベント詳細へGO!
建築・インテリア
建築監督科
-
07/18(土)
10:00~12:30, 14:00~16:30
1級建築士試験対策!手描き製図を練習!

※[通信制]建築科/建築士専科の開催はありません。9月以降に開催予定です。
申し込む
建築科
-
07/18(土)
10:00~12:30, 14:00~16:30
室内を3Dコーディネートで大改造!

※[通信制]建築科/建築士専科の開催はありません。9月以降に開催予定です。
申し込む
インテリア科
-
07/18(土)
10:00~12:30, 14:00~16:30
ドライフラワーにひと手間加え、インテリアオーナメントづくりをしよう!
.jpg)
※[通信制]建築科/建築士専科の開催はありません。9月以降に開催予定です。
申し込む